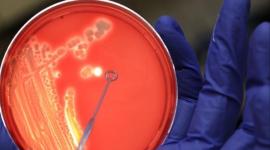

دراسة: تناول الزبادي بكثرة يمنحك خصراً نحيلاً
26 نوفمبر 2015
رام الله لن تضيء شجرة الميلاد هذا العام
26 نوفمبر 2015
مجمع الشفاء ينجح بإجراء عمليات قسطرة قلبية للأطفال
26 نوفمبر 2015
سرقة أدمغة من مستشفى وبيعها على "إيباي"
26 نوفمبر 2015
الزيتون.. تنوع في الأشكال والفوائد
26 نوفمبر 2015
البكتيريا المعوية قد تتحكم بالجوع
26 نوفمبر 2015
تشكيل لجنة لمتابعة تصدع مبنى الولادة في "الشفاء"
25 نوفمبر 2015
طفل أمريكي يتبرع بـ20$ لبناء مسجد فكانت المفاجأة
25 نوفمبر 2015
تمارين للسيطرة على نسبة السكر في الدم
25 نوفمبر 2015
في اسكتلندا.. مدرسة بتلميذ واحد
25 نوفمبر 2015
إطلاق رواية "ربيع 68" برام الله
25 نوفمبر 2015
دراسة تكشف عن مادة خطرة في الشوكولاتة
24 نوفمبر 2015
محاضرة بـ"الوفاء" حول المقياس الأمريكي لإصابات النخاع الشوكي
24 نوفمبر 2015
سياحة غزة توضح ماهية القطع الأثرية المكتشفة
24 نوفمبر 2015
لقاح يحسن فرص النجاة لمرضى سرطان المخ
24 نوفمبر 2015
الكوارث المناخية أودت بحياة 600 ألف شخص في 20 عاما
24 نوفمبر 2015
نجاح جراحة جديدة لتوسيع القناة الشوكية لمريضة بغزة
23 نوفمبر 2015
بالفيديو العثور على آثار ذهبية وفضية ُبغزة
23 نوفمبر 2015
عراك على "الرجل الأقبح" في زيمبابوي
23 نوفمبر 2015